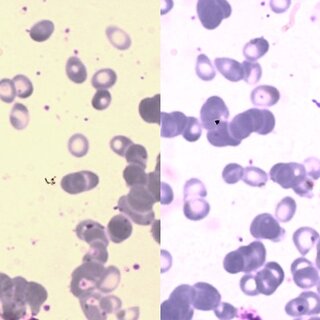

Síntesis de 3,4-Dihydropyrimidin-2-(1H)-ones/thiones a través de una vía de transferencia de un solo electrón/energía. Azul de metileno (MB+) como catalizador foto redox

Encuentra más información en nuestro repositorio digital El trabajo actual proporciona un método novedoso y ecológico para crear estructuras de dihidropirimidinona (DHPM) utilizando puntos cuánticos de carbono dopados con cobre (Cu-CQDs) como un catalizador heterogéneo eficaz y respetuoso con el medio ambiente en la búsqueda de un enfoque catalítico verde y sostenible. De acuerdo con los principios de la química verde, se demostró la eficacia catalítica de los Cu-CQDs en la reacción de Biginelli, produciendo derivados de DHPM en condiciones suaves y sin disolventes. Además, utilizando in silico DFT y estudios de acoplamiento molecular, los compuestos DHPM producidos fueron evaluados por primera vez para su capacidad de bloquear la enzima pepsina, demostrando robustas interacciones de unión dentro del sitio activo de la enzima. Sobre la base de los prometedores resultados de acoplamiento, todos los derivados de DHPM se sometieron a un ensayo enzimático in vitro, confirmando su potencial como inhibidores de pepsina eficaces con inhibición que oscilaba entre 1,99 0,9 M y 8,98 1,9 M en una concentración de 10 6 M. El valor IC50 obtenido de 1,99 0,9 10 6 M indicó que el compuesto RJ10 era el mejor inhibidor. Cu-CQDs catalizado DHPMs surgió como una nueva clase de inhibidores de pepsina con aplicaciones potenciales en la química medicinal se destaca por los conocimientos combinados computacionales y experimentales. Este estudio proporciona la vía para futuros desarrollos de derivados de DHPM como inhibidores de enzimas digestivas. Accede al artículo completo aquí
Anemia hemolítica autoinmune de crioagglutinina secundaria a infección por Mycoplasma pneumoniae en paciente con anemia perniciosa: informe de caso
Encuentra más información en nuestro repositorio digital Este informe describe el raro caso de un paciente con anemia hemolítica autoinmune debida a crioaglutininas secundarias a la infección por Mycoplasma pneumoniae, coexistiendo con anemia perniciosa. Un hombre de 56 años presentó una historia de diez días de tos y palidez mucocutánea. Estudios de laboratorio revelaron anemia megaloblástica con bajos niveles de vitamina B12, anticuerpos positivos contra el factor intrínseco y las células parietales, así como parámetros de hemólisis y una prueba directa de Coombs positiva para complemento (C3d) con crioaglutininas activas a bajas temperaturas. M. pneumoniae infección fue confirmada por inmunofluorescencia indirecta para IgM y IgG. Se administraron suplementos del complejo B intramuscular y doxiciclina durante 14 días, mejorando la hemoglobina y otros parámetros hematológicos en un plazo de cuatro semanas. Este caso destaca la complejidad diagnóstica en pacientes con anemias hemolíticas raras en el contexto de infecciones atípicas y subraya la importancia de un enfoque multidisciplinario para su diagnóstico y tratamiento adecuado. La coexistencia de la anemia hemolítica autoinmune mediada por crioagglutinina y la anemia perniciosa plantea desafíos diagnósticos y terapéuticos que son relevantes para la práctica clínica. Accede al artículo completo aquí
Signo de Fink: A characteristic perineal dermatoses of Kawasaki disease; Signo de Fink: una característica de la enfermedad de Kawasaki

Encuentra más información en nuestro repositorio digital Accede al artículo completo aquí
MXenes en ingeniería de tejidos y medicina regenerativa: avances, desafíos y perspectivas futuras

Encuentra más información en nuestro repositorio digital El atractivo de los materiales bidimensionales (2D) ha impulsado una ola de innovación en diversos ámbitos científicos, especialmente en el ámbito de las aplicaciones biomédicas y terapéuticas. Entre estos materiales extraordinarios, los MXenes destacan como nitruros y carburos de metales de transición con propiedades extraordinarias. Con baja toxicidad, amplia superficie, capacidad antibacteriana, biocompatibilidad, hidrofilicidad y una conductividad eléctrica impresionante, los MXenes son muy prometedores para una gran variedad de aplicaciones biomédicas, desde la bioimagen hasta la terapia del cáncer y más. A pesar de su enorme potencial, persisten los desafíos para garantizar la liberación controlada de fármacos, la estabilidad en entornos fisiológicos y la biodegradabilidad. Al aprovechar el poder transformador de la nanomedicina, las nanoláminas ultrafinas de MXene, meticulosamente elaboradas, emergen como nanosistemas inorgánicos versátiles, preparados para diversas funciones biomédicas. Posicionadas como candidatas óptimas para la medicina regenerativa y la ingeniería de tejidos, las MXene marcan una nueva era en la innovación sanitaria. Este artículo profundiza en los últimos avances logrados en el aprovechamiento de MXenes 2D para aplicaciones de ingeniería de tejidos y medicina regenerativa de vanguardia, al tiempo que arroja luz sobre los formidables obstáculos y las prometedoras perspectivas futuras que esperan ser exploradas con estos materiales extraordinarios. Accede al artículo completo aquí
Conversiones fotocatalíticas de CO2 en nanopartículas de cobre investigadas mediante cambios espectrales Raman utilizando redes neuronales convolucionales

Encuentra más información en nuestro repositorio digital Se emplea un proceso de aprendizaje profundo de red neuronal convolucional (CNN) para analizar datos de dispersión Raman in situ para la captura de CO2 y sus conversiones fotocatalíticas en nanoesferas huecas de sulfuro de cobre (CuSHNS) y nanocubos de cobre (CuNC) en solución de microalgas de Spirulina maxima. Los espectros Raman bajo luz visible a 633 nm en una solución microfluídica proporcionaron bandas marcadoras vibracionales representativas de características de doble enlace CO a ∼2100 cm−1 y vibraciones de flexión CH2/CH3 a ∼1400 cm−1 que están correlacionadas con productos de reducción de CO2 de monóxido de carbono (C1) y especies multicarbonadas como propanol (C3), butanol (C4), respectivamente. Los espectros Raman acumulados se entrenaron y analizaron para estimar las vías fotocatalíticas utilizando el algoritmo CNN. Se estudia la presencia de la microalga Spirulina maxima en la alteración de los procesos fotocatalíticos mediante el análisis de los cambios espectrales Raman colectivos. La principal observación es que los picos intensos de CO en los espectros Raman del CO₂ adsorbido por CuNC prácticamente desaparecieron tras el tratamiento con microalgas, mientras que su intensidad aumentó ligeramente en el caso de CuSHNS. El proceso de aprendizaje profundo de CNN para los espectros Raman fue eficaz para diferenciar los mecanismos fotocatalíticos de la conversión de CO₂ en las superficies de las nanopartículas. Accede al artículo completo aquí
Evaluación de la calidad de las directrices de práctica clínica para el manejo y tratamiento quirúrgico de la incontinencia urinaria femenina por estrés

Encuentra más información en nuestro repositorio digital Las directrices de práctica clínica (GPC) son herramientas desarrolladas para apoyar la toma de decisiones basada en la evidencia en el cuidado de la salud. Sin embargo, a pesar de la disponibilidad de GPC para el manejo quirúrgico de la incontinencia urinaria de estrés femenino (FSUI), su calidad metodológica no ha sido evaluada. El objetivo de este estudio fue evaluar la calidad metodológica de las directrices publicadas para el manejo quirúrgico de FSUI utilizando la herramienta AGREE II. Se realizó una búsqueda sistemática de los GPC publicados entre 2017 y 2023 en bases de datos como MEDLINE/PubMed, LILACS, Scopus y Trip Medical Database. La extracción de datos y la selección de directrices fueron realizadas independientemente por dos revisores, al igual que la evaluación utilizando el instrumento AGREE II. De los 1.459 registros iniciales, seis directrices cumplían los criterios de elegibilidad. Las puntuaciones para cada dominio evaluadas fueron las siguientes: alcance y finalidad (45,83%; SD: 22,69), participación de las partes interesadas (30,56%; SD: 29,03), desarrollo (48,56%; SD: 30,42), claridad de la presentación (58,80%; SD: 22,25), aplicabilidad (24,04%; SD: 26,36) e independencia editorial (44,87%; SD: 32,88). Uno de los seis GPC incluidos fue calificado como de alta calidad y recomendado para la práctica clínica. Se recomendaron tres GPC con modificaciones porque todavía había áreas que necesitaban mejora para mejorar su calidad, y dos GPC no fueron recomendadas para la práctica clínica porque los seis dominios evaluados obtuvieron puntajes por debajo del 60%. De acuerdo con estos hallazgos, es esencial que los nuevos GPC desarrollados para el manejo quirúrgico de la FSUI se adhieran a un mayor rigor metodológico para asegurar que las recomendaciones estén basadas en la mejor evidencia disponible. Además, las directrices deben tener en cuenta los valores del paciente y la experiencia clínica para mejorar y facilitar una toma de decisiones eficaz en materia de asistencia sanitaria. Accede al artículo completo aquí

